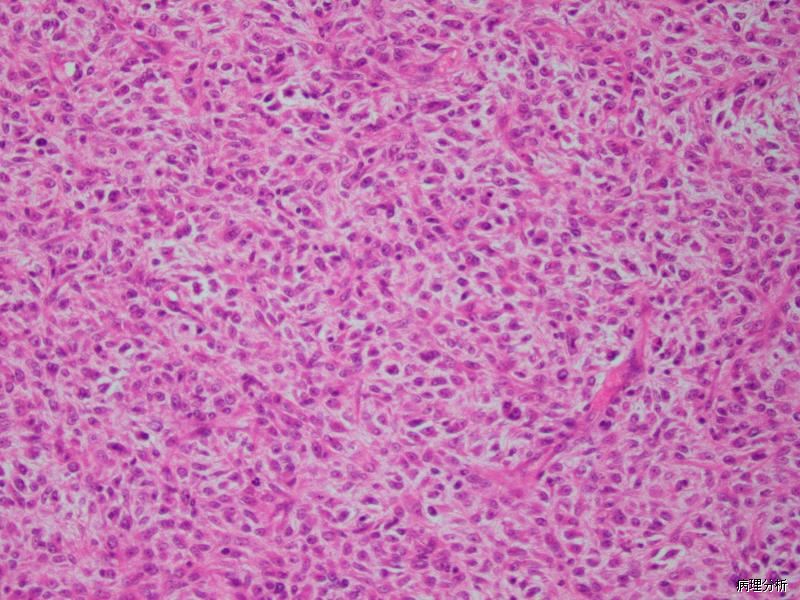

圆细胞脂肪肉瘤
Round Cell Liposarcoma
发病部位: 下肢、腹膜后
诊断要点:
其发病高峰年龄为 30 ~ 50 岁,好发于下肢深部的软组织内,特别是大腿内侧和胭窝;
瘤细胞多排列成片状或团块状,有时呈索状、梁状或腺样排列,与黏液性脂肪肉瘤区域之间可有移行;
细胞形态较为一致,呈小圆形,细胞周界清楚,胞质颗粒状或嗜伊红色,可见单泡状脂母细胞,偶见多泡状脂母细胞;
常和黏液性脂肪肉瘤成分混合存在,两者可有移行;
根据圆细胞成分在肿瘤内所占的比例,Evans 将黏液性脂肪肉瘤分为三级:Ⅰ 级为<10%,即通常所说的黏液性脂肪肉瘤;Ⅱ 级为 10%~ 25%,即混合性黏液性/圆细胞脂肪肉瘤;Ⅲ 级为>25%,即圆细胞脂肪肉瘤。
免疫组织化学染色:
S-100 常阳性。